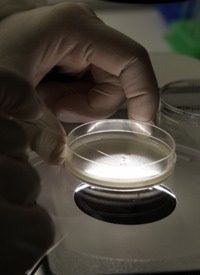
Judge Lifts Ban on Federal Funding of Embryonic Stem-cell Research

Judge Lifts Ban on Federal Funding of Embryonic Stem-cell Research
United States District Judge Royce Lambert ruled in August that the federal government should halt funding for embryonic stem-cell research conducted by the National Institutes of Health (NIH). However, yesterday’s Appeals Court ruling lifted the judge’s ban, allowing the government to continue funding until a final decision is reached on the legality of embryonic stem-cell research.
According to the three-judge panel on the United States Court of Appeals in Washington, D.C., the United States government “satisfied the standards required for a stay, pending appeal.”
Considered a highly controversial method of research, Medical News Today explains, “Embryonic stem cells are derived from a four or five day old human embryo that is in the blastocyst phase of development. The embryos are usually extras that have been created in IVF (in vitro fertilization) clinics where several eggs are fertilized in a test tube, but only one is implanted into a woman.”
Collecting stem cells from embryos left over from fertility treatment is fatal to the embryo, and the use of federal funds to do so is in violation of a 1996 law that prohibits the use of taxpayer dollars to destroy an embryo. To circumvent the law, batches of embryonic stem cells were collected using private funding. Because those batches continue to indefinitely reproduce in lab dishes, however, government policies dictate that using taxpayer dollars to collect the already created batches is acceptable.
In his August ruling, Judge Lamberth asserted that such policies were in violation of the intent of the 1996 law.
According to Dr. David Prentice, professor of life sciences at Indiana State University and founder of Do No Harm, The Coalition of Americans for Research Ethics, losing the embryonic stem-cells lines does not pose obstacles to cures derived from stem cells because adult stem cells (not gleaned from human embryos) are “much more effective at reaching the goals of therapeutic treatment.”
This fact has even been intimated by the NIH itself. A 2001 CNN article revealed, “Adult stem cells could provide certain benefits over embryonic stem cells, according to the National Institutes of Health.”
Following an order from President George W. Bush in August 2001, embryonic stem-cell research was limited to a small number of existing cell lines. Under President Bush, Congress attempted to pass legislation in support of tax-funded stem-cell research, but both pieces of legislation were vetoed by Bush.
In March 2009, President Obama provided broader federal funding for the research.
The Alliance Defense Fund is involved in the lawsuit that challenges the use of federal funds for embryonic stem-cell research. Steven Aden, senior legal counsel for the Alliance Defense Fund reacted to the Appeals Court decision. “We believe it’s a shame that they would rush to push funding of embryonic stem cell research, and a waste of taxpayer money.”
The NIH indicates that it will resume its research and evaluate applications from scientists who are seeking federal funding, i.e., taxpayer money, to conduct the research.
A statement released by the NIH revealed, “We are pleased with the court’s interim ruling, which will allow promising stem cell research to continue.”
The Huffington Post writes, “Scientists who already had received NIH grants had been told to continue working until their dollars ran out, but that 22 projects due to get yearly checks in September would have to find other money. Now the question is whether the NIH will finish the reviews required for those projects during what could be only a temporary reprieve.”
Because of the uncertainty of the Appeals Court ruling, embryonic stem-cell researcher Dr. George Daley stated, “I take no solace in the ruling because so much uncertainty remains about the future of human stem cell research. I won’t rest peacefully until there is a clear … vote of support from the Congress for this vital research.”
An August poll conducted by Rasmussen Report shows that 57 percent of Americans remain opposed to embryonic stem-cell research. A mere 33 percent indicated their support for the research. Seventy-eight percent of Republicans and 55 percent of Democrats oppose the research. Of pro-life Americans, 83 percent are opposed to embryonic stem-cell research.
Rasmussen Reports’ poll shows more Americans in favor of adult stem-cell research because the use of those cells shows “no rejection factors because they are derived from the same person.” Those polled cited statistics that revealed that adult stem cells “hold more promise in the cure of diseases much sooner.”
Medical News Today reports that the final decision determining whether or not federal funding of embryonic research will be permanently halted will be made by Judge Judith Rogers, an appointee of President Clinton, as well as Judge Thomas Griffith and Judge Brett Kavanaugh, both appointees of President George W. Bush.
Photo: AP Images





